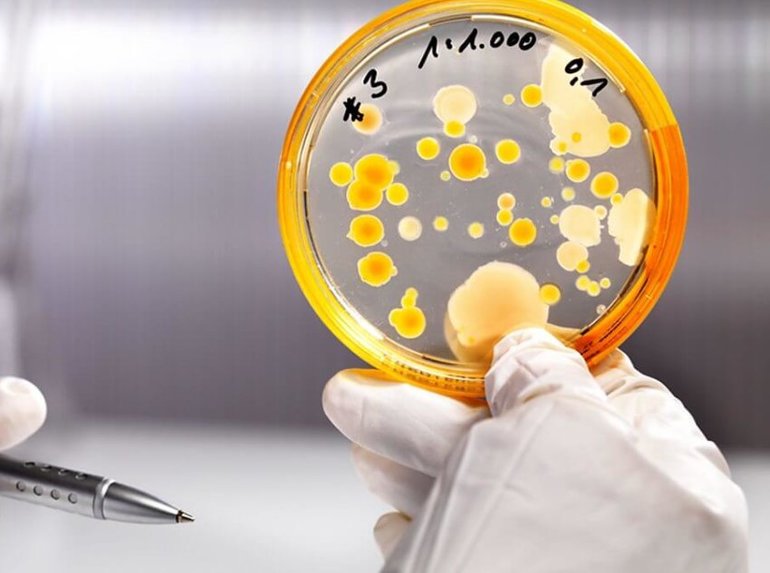
Распад эритроцитов

Гемолиз крови — процесс разрушения эритроцитов, который может серьезно повлиять на здоровье. Понимание причин, симптомов и методов лечения гемолиза важно для диагностики и терапии различных заболеваний. В статье рассмотрим основные факторы, способствующие гемолизу, его клинические проявления, а также подходы к диагностике и лечению, что поможет читателям ориентироваться в проблеме и своевременно обращаться за медицинской помощью.
Принцип классификации
Гемолиз начинается в момент, когда эритроциты достигают своего естественного срока жизни (4−5 месяцев), после чего они начинают погибать. Особенно опасным является быстрое разрушение этих клеток, что указывает на наличие патологии. Существует несколько типов гемолиза эритроцитов:
- Осмотический. Этот тип гемолиза происходит в специальных растворах, когда клетки теряют воду в окружающую среду. В результате сжатия возникают повреждения в клеточной мембране. Гемолиз, происходящий в гипотоническом растворе, сопровождается процессом цитолиза.
- Физический. Данный гемолиз связан с механическим повреждением мембран. Он может возникать из-за встряхивания или воздействия ультразвука. Этот процесс часто наблюдается при сдаче крови.
- Химический. В этом случае гемолиз обусловлен химическими реакциями различных веществ. К повреждениям могут привести сильные кислоты, жиры и растворители.
- Токсичный. Этот тип гемолиза возникает под воздействием токсинов, вырабатываемых различными микроорганизмами.
- Иммунологический. Данный гемолиз считается характерным в случаях, когда обнаруживается несовместимость при переливании крови.
Гемолизин — это вещество, способствующее разрушению эритроцитов. В зависимости от типа гемолизина, врачи различают полное и частичное разрушение гемоглобина, а также случаи, когда гемолиз отсутствует.

Врачи отмечают, что гемолиз крови может быть вызван различными факторами, включая аутоиммунные заболевания, инфекции, токсические вещества и наследственные нарушения. Симптомы варьируются от усталости и бледности до желтухи и увеличения селезенки. Важно, что у мужчин и женщин проявления могут быть схожими, однако некоторые причины, такие как беременность, могут влиять на женщин по-особенному. Лечение гемолиза зависит от его причины: в некоторых случаях достаточно устранить провоцирующий фактор, в других может потребоваться применение кортикостероидов или переливание крови. Врачи подчеркивают важность ранней диагностики и индивидуального подхода к каждому пациенту для достижения наилучших результатов.
Описание in vitro и in vivo
Когда процесс проходит in vitro, эритроциты быстро разрушаются, что приводит к высвобождению гемоглобина. У некоторых пациентов наблюдается освобождение целых эритроцитов, что вызывает желтушность, сменяющуюся оттенком «ржавчины».
В ходе этого процесса формируется цероид, а затем появляется гематома. Подобные проявления могут быть характерны для малярии и гиперспленизма. Также могут наблюдаться признаки гемолитической анемии, такие как гемоглобинурия и снижение количества эритроцитов в крови.
В условиях in vivo разрушение эритроцитов может быть вызвано как самими клетками, так и внешними факторами. Высвобожденный гемоглобин связывается с гаптоглобином, а при его распаде образуются ферритин и билирубин.
Осаждённый гемоглобин может привести к повреждению почек. Высокий уровень гемолиза часто сопровождается гемосидерозом. Если количество высвобожденного гемоглобина превышает способность гаптоглобина к связыванию, это состояние называется гемоглобинемией. В норме его значение варьируется в пределах 0,3−2 у.е.
https://youtube.com/watch?v=SX3S7MGKaoU
| Причина | Симптомы | Лечение |
|---|---|---|
| Аутоиммунные заболевания (аутоиммунная гемолитическая анемия, системная красная волчанка) | Бледность кожи, желтуха, слабость, одышка, учащенное сердцебиение, темная моча, увеличение селезенки | Кортикостероиды, иммунодепрессанты, спленэктомия (удаление селезенки), переливание крови |
| Наследственные заболевания (серповидноклеточная анемия, талассемия, дефицит Г6ФД) | Хроническая усталость, бледность, желтуха, боли в костях и суставах, увеличение селезенки, частые инфекции | Переливание крови, хелатирующая терапия (для удаления избытка железа), спленэктомия, трансплантация костного мозга (в некоторых случаях) |
| Инфекции (малярия, сепсис, вирусные инфекции) | Лихорадка, озноб, слабость, желтуха, темная моча, боли в животе, увеличение селезенки | Антибиотики, противомалярийные препараты, противовирусные средства, поддерживающая терапия, переливание крови |
| Лекарственные препараты (некоторые антибиотики, противомалярийные средства, НПВС) | Внезапное появление бледности, желтухи, слабости, темной мочи после приема препарата | Отмена препарата, поддерживающая терапия, переливание крови (при необходимости) |
| Токсины и яды (укусы змей, отравление свинцом, грибами) | Тошнота, рвота, боли в животе, желтуха, темная моча, почечная недостаточность | Антидоты, поддерживающая терапия, переливание крови, диализ (при почечной недостаточности) |
| Механическое повреждение эритроцитов (искусственные клапаны сердца, маршевая гемоглобинурия) | Бледность, слабость, темная моча, увеличение селезенки | Устранение причины механического повреждения, поддерживающая терапия, переливание крови |
| Трансфузионные реакции (несовместимость групп крови при переливании) | Лихорадка, озноб, боли в пояснице, одышка, падение артериального давления, темная моча | Немедленное прекращение переливания, поддерживающая терапия, диуретики, переливание крови совместимой группы |
| Пароксизмальная ночная гемоглобинурия (ПНГ) | Темная моча по утрам, бледность, слабость, боли в животе, тромбозы | Экулизумаб, переливание крови, антикоагулянты |
Этиология явления
Существует несколько факторов, способствующих разрушению эритроцитов в крови. Например, это может произойти при переливании несовместимой крови. Другие причины гемолиза у мужчин, женщин и детей:
- острые инфекционные заболевания, токсические вещества;
- изоиммунная гемолитическая анемия.
Патологический гемолиз может возникнуть в результате отравления уксусом или ядовитыми веществами. Резкое ухудшение состояния крови часто связано с попаданием в неё ртути или тяжёлых металлов. Подобные симптомы также наблюдаются при токсоплазмозе и вирусном гепатите.
Заболевания, вызванные стрептококками и паразитами плазмодия, ослабляют иммунную систему, что может привести к гемолизу. Поражение крови также связано с серповидной анемией и бесконтрольным использованием лекарственных средств.
https://youtube.com/watch?v=3jSknhVI3Ns
Определение при беременности
Нормальные показатели гематокрита у новорожденных в возрасте до одного месяца варьируются от 0,56 до 0,45, у детей от года до 15 лет — от 0,35 до 0,39, а у подростков составляют 0,47. Отклонения от этих значений могут указывать на гемолиз, который может проявляться сразу после рождения. Это часто связано с несовместимостью антител матери и ребенка. Симптомы включают ослабленный иммунитет, отеки, анемию и желтуху. Патология может развиваться как в сосудах, так и в клетках.
Определение несовместимости крови между матерью и плодом осуществляется врачом в процессе беременности. В случае подтверждения такого диагноза требуется внутриутробное лечение. Гемолитическая болезнь чаще всего наблюдается у недоношенных детей.
В дополнение к переливанию крови назначаются глюкокортикостероиды. В качестве лечения может быть использован Кортизон.
Дальнейшая терапия основывается на клинической картине состояния пациента. В план лечения включаются переливание крови и гормональная терапия. Грудничков переводят на специализированные смеси. Если состояние ребенка ухудшается, лечение проводится в стационарных условиях.
https://youtube.com/watch?v=-i2KHYE_088
Симптомы и диагностика
В здоровом организме процесс биологического гемолиза эритроцитов проходит без каких-либо проявлений. Однако при остром или патологическом распаде клеток могут возникать клинические симптомы.
Признаки острого гемолиза:
- пониженное артериальное давление;
- бледность кожи;
- повышение температуры тела;
- тошнота и рвота.
Лабораторные анализы показывают прогрессирующую анемию, поскольку наблюдается снижение количества тромбоцитов, рост уровня билирубина и нарушение процессов свёртываемости крови. При появлении внешних симптомов пациента направляют на полное обследование. Для диагностики гемолиза измеряют уровень гемоглобина и билирубина в крови.
Чтобы оценить плотность мембран эритроцитов, пациенту проводят тест на осмотическую резистентность. После взятия крови рассчитывается индекс гемолиза (HI), который позволяет определить содержание гемоглобина в крови. Нормальные значения HI для мужчин и женщин варьируются от 0,4 до 0,52 и от 0,37 до 0,49 соответственно.
Эритроциты, которые завершили свой жизненный цикл, имеют форму шара. Наличие таких клеток свидетельствует о повышении индекса сферичности и развитии анемии. Молодые эритроциты, только что вышедшие из костного мозга, характеризуются низким индексом сферичности. При значительном распаде эритроцитов рекомендуется повторная сдача крови, чтобы исключить возможность ошибки при её заборе.
https://youtube.com/watch?v=rNHCfXv9_vA
Проведение тестов
Для диагностики гемолиза пациенту назначается ряд тестов. Метод Кумбса позволяет обнаружить антитела к антигенам эритроцитов. В процессе исследования специальная сыворотка добавляется к очищенной крови пациента, и образование осадка свидетельствует о наличии иммуноглобулинов.
Исследование может проводиться двумя способами:
- Прямой метод. Он позволяет выявить эритроциты, покрытые веществами in vivo.
- Непрямой метод. С его помощью можно обнаружить антиэритроцитарные антитела в крови людей, регулярно сдающих анализы.
Для оценки устойчивости клеток к осмотическому давлению требуется специальное тестирование. В норме минимальная концентрация составляет 0,4% NaCl, а максимальная — 0,3% NaCl. При отсутствии глюкозо-6-фосфатдегидрогеназы снижается уровень восстановления глутатиона, что может привести к повреждению эритроцитов под воздействием кислорода.
Другие диагностические процедуры:
- Гама-тест помогает выявить пароксизмальную ночную гемоглобинурию. Во время инкубации эритроцитов в сыворотке происходит активация комплемента, что приводит к гемолизу патологических эритроцитов.
- Проточная цитометрия. Этот анализ необходим для определения белков, связанных с клеточной мембраной.
На результаты тестов могут влиять различные факторы, например, недостаточная стерильность. При разрушении эритроцитов в плазму попадают вещества, концентрация которых значительно превышает норму. Если в состав внутриклеточной жидкости содержится избыточное количество глюкозы или билирубина, уровень исследуемого вещества будет выше установленной нормы.
https://youtube.com/watch?v=WdBvknfIeyU
Терапия и профилактика
Для лечения острого гемолиза необходима неотложная медицинская помощь в стационаре. В критических случаях пациента переводят в отделение реанимации. Основная цель терапии заключается в устранении причины гемолиза. Для удаления токсичных веществ проводится промывание желудка и очищение кишечника с помощью клизмы.
При наличии почечной или печеночной недостаточности назначается симптоматическая терапия, включая гемодиализ. Жизненно опасные состояния требуют интенсивной терапии. В таких случаях может быть выполнено переливание крови. Если наблюдается значительная потеря эритроцитов, вводится специальная эритроцитарная масса, которая служит заменой трансфузии крови.
При диагностировании врождённой анемии проводится стимуляция производства красных кровяных клеток. Гормональные препараты могут помочь предотвратить воспалительные процессы и высокое артериальное давление. Лечение наследственной анемии гемолитического типа является более сложным, и в некоторых ситуациях может потребоваться удаление селезёнки.
Если возникают симптомы аутоиммунного гемолиза, рекомендуется применение глюкокортикостероидов, таких как Преднизолон. Гемолитический криз в тяжёлой форме может быть купирован с помощью Реоглюмана. При необходимости кровь очищается методом плазмафереза с внутривенным введением Гепарина. Это комплексное лечение направлено на удаление свободного гемоглобина из организма.
Для профилактики почечной недостаточности рекомендуется принимать Диакарб и Бикарбонат натрия. При отсутствии эффективного лечения или его не проведении может развиться гемолитическая анемия, которая сопровождается изменениями в количестве лейкоцитов и тромбоцитов.
Также может возникнуть желчнокаменная болезнь. Для предотвращения осложнений и самого гемолиза настоятельно рекомендуется избегать самолечения. Не следует употреблять в пищу неизвестные грибы и ягоды. В случае укуса змеи необходимо немедленно обратиться за квалифицированной медицинской помощью.

Влияние гемолиза на другие органы и системы
Гемолиз крови, представляющий собой разрушение эритроцитов, может оказывать значительное влияние на различные органы и системы организма. Это состояние приводит к высвобождению гемоглобина в плазму, что может вызвать ряд вторичных эффектов, затрагивающих как кровеносную, так и другие системы.
Одним из основных органов, подверженных влиянию гемолиза, является печень. При разрушении эритроцитов происходит увеличение уровня билирубина в крови, что может привести к желтухе. Печень, отвечающая за метаболизм билирубина, может испытывать перегрузку, что в свою очередь может вызвать воспалительные процессы и даже привести к печеночной недостаточности при тяжелых формах гемолиза.
Сердечно-сосудистая система также страдает от последствий гемолиза. Высвобожденный гемоглобин может связываться с оксидом азота, что приводит к нарушению сосудистого тонуса и может вызывать гипертензию. Кроме того, анемия, вызванная гемолизом, приводит к снижению кислородной емкости крови, что может вызвать ишемические процессы в органах и тканях, особенно в сердце и головном мозге.
Почки также подвержены риску при гемолизе. Высокий уровень свободного гемоглобина может привести к повреждению почечных канальцев, что в свою очередь может вызвать острое повреждение почек. Это состояние может проявляться в виде олигурии или анурии, а также повышенного уровня креатинина в крови.
Кроме того, гемолиз может оказывать влияние на иммунную систему. Высвобожденные компоненты эритроцитов могут активировать иммунные реакции, что может привести к развитию аутоиммунных заболеваний. Это состояние может быть особенно опасным, так как может вызвать дальнейшие осложнения и ухудшение общего состояния пациента.
Наконец, нервная система также может пострадать от последствий гемолиза. Снижение уровня кислорода в крови может привести к когнитивным нарушениям, головным болям и даже к потере сознания. Хроническая гипоксия может оказывать длительное влияние на мозговую деятельность, что в свою очередь может привести к серьезным неврологическим расстройствам.
Таким образом, гемолиз крови является серьезным состоянием, которое может оказывать многогранное влияние на различные органы и системы организма. Важно своевременно диагностировать и лечить это состояние, чтобы минимизировать риск осложнений и сохранить здоровье пациента.
Психологические аспекты и качество жизни пациентов
Гемолиз крови, представляющий собой разрушение эритроцитов, может оказывать значительное влияние не только на физическое состояние пациентов, но и на их психологическое здоровье и общее качество жизни. Понимание этих аспектов имеет важное значение для комплексного подхода к лечению и поддержке пациентов, страдающих от данного состояния.
Пациенты с гемолизом часто сталкиваются с хронической усталостью, слабостью и другими физическими симптомами, которые могут вызывать чувство беспомощности и депрессии. Постоянная борьба с недомоганием может привести к снижению мотивации и ухудшению настроения, что, в свою очередь, может усугубить физическое состояние. Психологические аспекты, связанные с гемолизом, могут включать в себя:
- Страх и тревога: Пациенты могут испытывать страх перед возможными осложнениями, связанными с гемолизом, такими как анемия или необходимость в трансфузиях крови. Это может вызывать постоянное беспокойство о своем здоровье и будущем.
- Социальная изоляция: Из-за физического состояния многие пациенты могут ограничивать свои социальные контакты, что приводит к чувству одиночества и изоляции. Это может негативно сказаться на их эмоциональном состоянии и качестве жизни.
- Снижение самооценки: Хронические заболевания, такие как гемолиз, могут вызывать у пациентов чувство неполноценности и низкой самооценки, особенно если они не могут выполнять привычные действия или участвовать в общественной жизни.
Качество жизни пациентов с гемолизом может значительно варьироваться в зависимости от тяжести заболевания, наличия сопутствующих заболеваний и уровня поддержки со стороны семьи и медицинских работников. Важно, чтобы медицинские специалисты не только лечили физические симптомы, но и учитывали психологические аспекты, предлагая пациентам комплексную поддержку.
Психологическая поддержка может включать в себя:
- Психотерапия: Индивидуальные или групповые сеансы с психологом могут помочь пациентам справиться с эмоциональными трудностями, связанными с их состоянием.
- Группы поддержки: Участие в группах поддержки может предоставить пациентам возможность общаться с людьми, сталкивающимися с аналогичными проблемами, что может снизить чувство изоляции и повысить уровень понимания.
- Образовательные программы: Информирование пациентов о их состоянии и методах его управления может помочь снизить уровень тревоги и повысить уверенность в себе.
Таким образом, комплексный подход к лечению гемолиза крови должен включать в себя не только медицинские, но и психологические аспекты, что позволит улучшить общее качество жизни пациентов и помочь им справиться с эмоциональными трудностями, связанными с их состоянием.
Перспективы исследований и новые методы лечения
Исследования в области гемолиза крови продолжают развиваться, открывая новые горизонты для диагностики и лечения этого состояния. В последние годы ученые сосредоточили свои усилия на изучении молекулярных механизмов, приводящих к гемолизу, что позволяет лучше понять причины заболевания и разработать более эффективные методы терапии.
Одним из перспективных направлений является использование генетических исследований для выявления предрасположенности к гемолизу. Генетические тесты могут помочь определить наличие мутаций, которые влияют на стабильность эритроцитов, что, в свою очередь, может привести к более ранней диагностике и индивидуализированному подходу к лечению.
Кроме того, ученые активно исследуют новые лекарственные препараты, направленные на предотвращение разрушения эритроцитов. Например, разрабатываются молекулы, которые могут стабилизировать мембраны красных кровяных клеток, уменьшая их подверженность гемолизу. Эти препараты могут стать важным дополнением к существующим методам лечения, таким как кортикостероиды и иммуносупрессоры.
Также стоит отметить, что в последние годы наблюдается рост интереса к использованию биологических препаратов, таких как моноклональные антитела. Эти препараты могут быть направлены на специфические молекулы, участвующие в патогенезе гемолиза, что позволяет более точно воздействовать на механизм заболевания и снижать риск побочных эффектов.
Важным аспектом будущих исследований является изучение влияния образа жизни и диеты на развитие гемолиза. Исследования показывают, что определенные продукты питания и добавки могут оказывать защитное действие на эритроциты, что открывает новые возможности для профилактики и лечения гемолиза.
Наконец, необходимо отметить, что развитие технологий, таких как геномное редактирование и клеточная терапия, может в будущем привести к революционным изменениям в подходах к лечению гемолиза. Эти методы могут позволить не только устранить симптомы, но и воздействовать на причины заболевания на клеточном уровне.
Таким образом, перспективы исследований и новые методы лечения гемолиза крови у мужчин и женщин обещают значительные улучшения в качестве жизни пациентов и эффективность терапии. Однако для достижения этих целей необходимо продолжать активные исследования и клинические испытания, чтобы подтвердить безопасность и эффективность новых подходов.